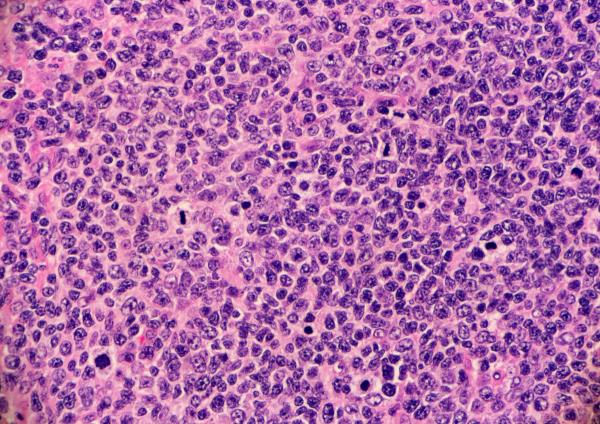
Image Credit: Adobe Stock Images/Lisa. High grade follicular lymphoma with marginal zone differentiation.

Metrics & Benchmarks
Latest News

FDA Approves Imfinzi Plus FLOT for Early and Locally Advanced Gastric and GEJ Cancers

The CRA Role’s Co-evolution With Clinical Trial Technology

ACT Brief: AI in Clinical Research, FDA Gene Therapy Approval, and High-Performing Hospital Partnerships

FDA Clears Itvisma as First Gene Therapy for Adolescents and Adults With SMA

Is Artificial Intelligence Coming for Clinical Research?

Shorts










Podcasts
Videos
All News

In today’s ACT Brief, we examine how AI and functional service partners are reshaping global pharmacovigilance, look at new data on how investigative sites are investing in and integrating digital solutions, and explore how Trialbee assesses ROI across emerging multi-touch recruitment platforms.

AI-enabled automation is rapidly moving into routine pharmacovigilance operations, streamlining case intake and processing, reducing longstanding adoption barriers, and driving new efficiencies as sponsors and functional service provider partners scale safety workflows.

A new global Tufts CSDD survey of 387 investigative site professionals reveals broad experience with digital and decentralized trial tools, growing site-driven technology investments, and strong support for remote data collection—while highlighting persistent burdens tied to fragmented systems, training demands, and financial strain.

How pharma–hospital partnerships can overcome operational, financial, and organizational barriers to build high-performing clinical trial programs that expand access, accelerate accrual, and strengthen research capacity across both academic and community settings.

Explore methods to evaluate recruitment performance across multiple platforms, including engagement tracking, conversion analysis, and data-driven optimization for emerging digital spaces.

New 48-week results from the Phase IIIb APEX trial show Tremfya delivers sustained radiographic protection and deeper clinical responses in active psoriatic arthritis, reinforcing its potential as an early, structural-sparing therapy.

Examine real-world examples of patient engagement through less conventional channels and see how targeted campaigns can reach high-quality participants even in low-volume or emerging platforms.
Epkinly plus rituximab and lenalidomide is the first bispecific antibody combination FDA-approved for relapsed or refractory follicular lymphoma, backed by Phase III data showing substantially improved disease control over standard therapy.

Emerging applications of AI/ML, automation, and digitization are helping sponsors cut clinical trial start-up times to as little as four weeks, reduce data errors, and enhance patient engagement—demonstrating how tech-enabled processes are reshaping trial efficiency and experience across the study lifecycle.

Understand the regulatory and policy considerations for running clinical trial recruitment campaigns on nontraditional or entertainment-focused platforms, and how ongoing collaboration with ad teams ensures compliant, effective outreach.

Phase III HERIZON-GEA-01 trial results show Ziihera combinations, with or without tislelizumab, significantly improve progression-free and overall survival in patients with HER2-positive advanced gastroesophageal adenocarcinoma, positioning these regimens as potential new first-line standards of care.

In today’s ACT Brief, we look at how Trialbee evaluates nontraditional digital platforms for patient recruitment, review new 48-week data from J&J’s APEX trial of Tremfya in psoriatic arthritis, and explore how agentic AI is poised to reshape commercial operations in life sciences.

Learn how demographic and behavioral insights inform platform-specific messaging, creative formats, and call-to-action strategies to engage patients and caregivers effectively across diverse digital channels.

New 48-week results from Johnson & Johnson’s Phase IIIb APEX trial show Tremfya delivers durable symptom improvement, slows radiographic progression, and maintains a consistent safety profile in biologic-naïve psoriatic arthritis patients—supporting J&J’s sBLA to expand the therapy’s label.

Explore which factors—audience relevance, content fit, and engagement quality—determine the best use of platforms like TikTok, Reddit, and Spotify for targeted patient recruitment campaigns.
























.png)



.png)



.png)
.png)
